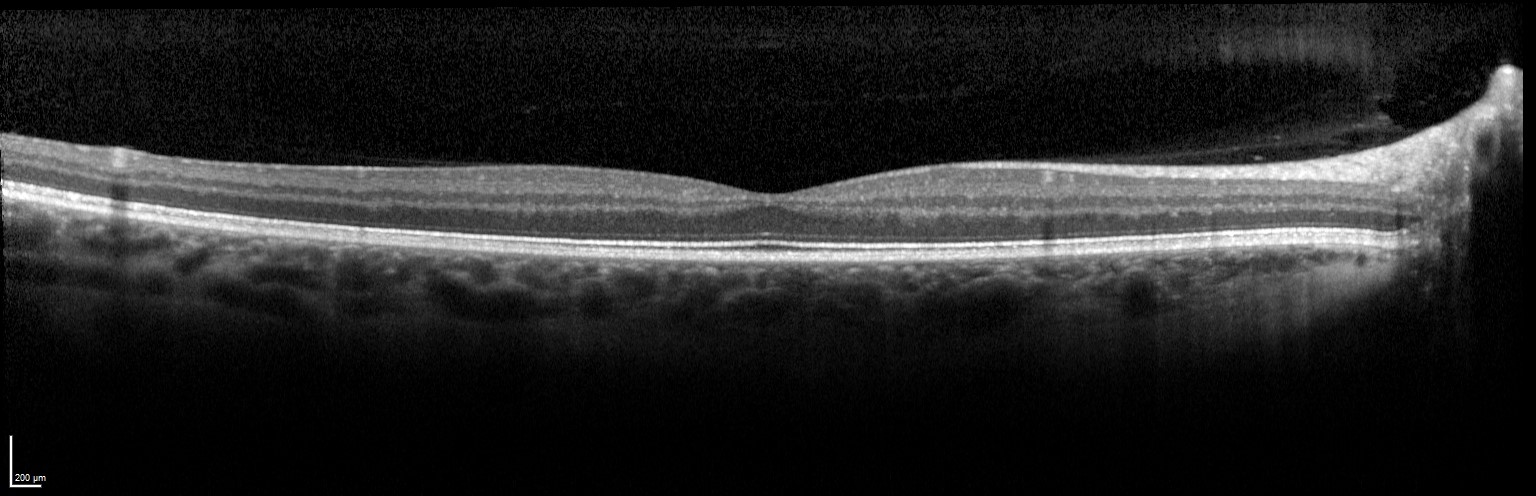

Anterior Segment Imaging
(Optical biometry)
IOLMaster 700
The IOLMaster 700 (Carl Zeiss Meditec AG, Germany) allows fast and accurate measurements of the axial eye length and corneal curvature using partial coherence interferometry. It is used for precise IOL power calculations.

Lenstar
The Lenstar (Haag-Streit, USA) provides laser interferometric biometry of the entire eye, precise keratometry, astigmatism and axis measurement, WtW and pupillometry measurement.

IOL Master 500
The IOL Master 500 (Carl Zeiss Meditec AG, Germany) is a non-contact optical device that automatically measures the distance from the corneal vertex to the retinal pigment epithelium by partial coherence interferometry.

(Slitlamp cameras)
Retroillumination camera
The Retroillumination camera consists of a digital color camera (Canon EOS 5D Mark II) connected to a slitlamp through a fibreoptic cable (both Carl Zeiss Meditec AG, Germany) for acquisition of high-quality digital images for PCO assessment (Digital Coaxial Retroillumination Photography, DCRP).

Slitlamp camera
The slitlamp camera consists of a digital color camera (Canon EOS 5D) connected to a slitlamp (Haag-Streit D900).

(Endothelial Cell Density Measurement / Confocal Microscopy)
Cellcheck 20
The Cellcheck (Konan Medical, USA) is a non-contact specular microscope for measurements of corneal endothelial cell density.

HRT3 (Heidelberg Retina Tomograph)
The Heidelberg Retina Tomograph (HRT; Heidelberg Engineering, Germany) in combination with a Rostock Cornea Modul (RCM) offers high definition, confocal microscopy images of the different layers of the cornea.

(Measurement of IOL tilt and decentration)
Dynamic Purkinjemeter
The Purkinjemeter (Cambridge, United Kingdom) uses a high speed camera working at 200 frames per second to allow measurement of lens and IOL wobbling in phakic and pseudophakic patients.

Purkinjemeter
The Purkinjemeter (Murcia, Spain) measures IOL tilt and decentration by capturing and recording the Purkinje images of a semi-circular ring of LEDs.

(Flare measurement)
Laser flare meter FM-600
The Laser flare meter FM-600 (Kowa, Japan) is a non-contact device for in vivo quantitative measurement of aqueous flare in the anterior chamber of the eye.

Posterior Segment Imaging
(OCT)
Spectralis OCT
The Spectralis OCT (Heidelberg Engineering, Germany) is a Spectral-domain optical coherence tomography device combined with scanning laser ophthalmoscope (SLO). It is a diagnostic device for high-resolution imaging of the retina, and with an extra module, also for the anterior segment.
DRI OCT Triton
The DRI OCT Triton is a combined anterior and posterior Swept Source OCT (ssOCT), which incorporates full colour high resolution fundus photography and fluorescence angiography.

Rescan 700
The Rescan 700 (Carl Zeiss Meditec AG, Germany) is a real-time high definition optical coherence tomography (OCT) device integrated into a surgical microscope.

California
California (Optos Inc., United Kingdom) was developed for medical imaging and is a standard for retinal screening programs. California is available in multiple configurations and multiple imaging modality options. California produces a 200°, single-capture retinal image of unrivaled clarity in less than ½ second and is changing the management of diseases including Geographic Atrophy, DR, AMD, and uveitis.

(Fundus photography)
bon Cobra
The bon Cobra (bon Optic, Germany) is a non-mydriatic digital fundus camera, that realizes digital fundus imaging of high resolution and fine gradation.

Daytona Plus
The Daytona plus (Optos Inc., United Kingdom) provides ultra-widefield digital high-resolution retinal images of 200 or up to 82% of the retina

Visual Function / Quality
(Vision tests)
ETDRS charts
The ETDRS (Early Treatment of Diabetic Retinopathy Study) chart (Precision Vision, USA) has equal number of letters in each line, similar and uniform legibility of each line and is considered the most accurate and a standard method of precise visual acuity recording.

IReST
The International Reading Speed Texts (IReST, Precision Vision, USA) are standardized texts of equal length, difficulty, and linguistic complexity, with a set of 10 paragraphs of text for repeated measurements, meeting the everyday life reading demands.

Optec Vision Tester 6500P
The Optec Vision Tester 6500P (Stereo Optical Inc., USA) offers visual screening under a variety of conditions including monocular, binocular, near and distance. It can also function as a test for contrast vision under mesopic or photopic conditions as well as with or without glare.

ETDRS Contrast Sensitivity Charts
The ETDRS Contrast Sensitivity Charts (Good Lite, USA) utilize letters with reducing contrast sensitivity thresholds (1.25%, 2.5%, 5%, 10%, 25%)

(Binocular and stereo testing)
Aston Halometer
The Aston Halometer (Aston University, UK) comprises a bright light-emitting-diode (LED) source in the center of an iPad to allow quantification of glare.

Stereo Fly Stereotest
The Stereo Fly Stereotest (Stereo Optical Co. Inc., USA) is an effective and easy-to-use test for the assessment of depth perception (stereopsis).

Stereogram Test App
The Stereogram Test App (McGill University, Canada) is an application for iPad or a 3D-Laptop that enables quantification of stereo vision at different distances.

Worth Four Dot Test
The Worth Four Dot Test (GIMA s.p.a., Italy) is a test for the assessment of binocular vision and binocular single vision.

(Reading Speed)
Eyelink
The Eyelink Eyetracker (SR Research Ltd., Canada) is a precise and accurate video-based eye tracker using video oculography to record eye movements from both eyes simultaneously during reading.

Salzburg Reading Desk (SRD)
The Salzburg Reading Desk (SRD Vision, Austria) allows accurate measurement of the reading acuity and reading speed, taking into account the patient’s individual reading distance and other distinct parameters as reading time, luminance, contrast, and reading angle.

(Perimeter)
Compass
Compass (Icare Finland Oy) is an automated perimeter combined with an active retinal tracker and a scanning ophthalmoscope. This advanced technology provides retinal sensitivity and fixation analysis, as well as TrueColor Confocal imaging of the retina.

RAPDx
The RAPDx (Konan Medical, USA) utilizes a high-definition, machine-vision system under controlled infrared conditions to present monocular visual stimuli while recording binocular pupil responses.

(Autorefractor)
Autorefractor (RM-8800)
The RM-8800 autorefractor (Topcon, Japan) provides an automated objective measurement of refractive error.

(Aberrometry)
Osiris
Osiris aberrometer (CSO, Italy) is an electro-medical system for measuring corneal and ocular aberrations, for use in ophthalmological diagnosis.

Other
(Ultrasound)
Aviso S
The Aviso S Ultrasound Platform (Quantel Medical, France) offers high resolution standardized digital ultrasound imaging.

(IOP measurement)
Icare tonometer
The Icare tonometer (Icare Finland Oy, Finland) is based on a rebound measuring principle that enables measurement of the intraocular pressure (IOP).

(Stress Measurement)
Neuromaster
The Neuromaster (Insight Instruments, Germany) can be used for Biofeedback measurement, including EMG, EKG, Breathing and Sweat Gland activity.

(Dry eye)
Meibography
Meibography is a device to examine the structure of meibomian glands. After eversion of the eyelids an infrared camera is used to take a picture of the glands. Thereafter area of loss of meibomian gland can be measured using the meiboscore.


